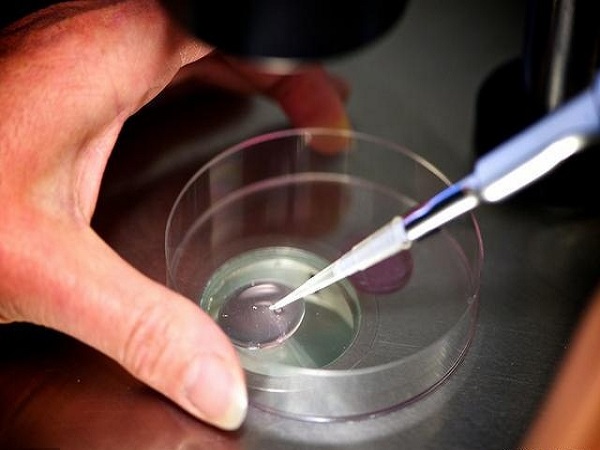

子宫憩室做试管的真实经历分享,有积液一次成功几率不高
- 试管婴儿经验
- 2023-04-03 09:16
说起子宫憩室相信很多人都并不是很了解,其实子宫憩室指的就是剖腹产手术后子宫切口愈合不良,子宫瘢痕处的肌层变薄,形成了与宫腔相通的凹陷和缝隙。子宫憩室对于子宫来说是一个巨大的危害,会直接影响女性生育,降低自然生育的几率,但可以选择试管婴儿。需要知道的是,如果子宫憩室并且有积液的话试管一次成功的几率是很低的,需要先手术治疗在做试管。
子宫憩室是剖腹产手术后子宫切口愈合不良而导致的
先怀孕,后付款-出生才是硬道理47岁1个卵泡一次成功经验分享不出国做三代-疫情下的试管新对策57岁供卵试管婴儿成功经验分享
助孕交流群
方法/步骤
子宫憩室的发生率其实还是比较高的,在19.4%-88%之间不等,存在子宫憩室的患者大多都没有明显的临床症状。有症状的患者是非常少的,如果女性出现了月经淋漓不尽、慢性盆腔痛、痛经或者是继发性不孕的话,就都需要及时到医院进行检查,很可能是存在子宫憩室的情况,需要尽快进行治疗才能够避免影响生育。
月经淋漓不尽是憩室的症状之一
子宫憩室试管成功案例
子宫憩室有积液其实是属于比较严重的,虽然说子宫憩室可以做试管婴儿,但是如果有有积液的话就不能够进行试管移植,不仅会影响胚胎的着床,而且即使移植成功了也可能会出现子宫破裂的情况,造成更大的危害。但是需要知道的是,子宫憩室做试管的成功率其实还是比较高的,临床上成功的案例也不少,下面就给大家分享几个:
积极配合医生治疗试管成功的几率并不低
网友一:我一胎就是剖腹产的,后来想生二胎的时候怎么都怀不上,好不容易怀上了也在孕初期的时候就流产了,去医院检查才发现那是我有子宫憩室,医生建议我做试管,和家人商量之后就走上了试管之路,因为我自己还是比较年轻的身体素质比较好,在治疗期间也是积极的配合医生,因此移植了一次就成功怀上了,现在二宝也已经1岁了,还是非常幸运的;
网友二:我是体检的时候发现自己有子宫憩室而且还有积液,所以导致我备孕一年多都没有怀上二胎,为了尽快怀孕我和老公就选择了做试管,本来是想直接进行移植的,但是医生说因为我子宫憩室有积液会影响胚胎着床,所以就先手术加药物治疗了憩室,在积液完全排完之后才进行了试管移植,做了两次移植都失败了,在第三次的时候才成功;
网友三:子宫憩室做试管婴儿是需要保持好的心态的,我前两次就是因为心态不好,总是非常焦虑和担心,所以就失败了,第三次的时候我已经是摆烂的心态了,管他的能成就成不能成大不了再来一次,结果第三次移植就成功着床了,现在孩子已经两个月大了。
Tips:
由此可见,子宫憩室做试管婴儿的成功率其实并不低,并且成功的案例也有很多。另外在试管期间除了心态很重要之外,还应该积极的配合医生进行治疗,多吃有营养的食物,这样才能够提高试管的成功率。
子宫憩室有积液试管一次成功
子宫憩室有积液就说明憩室比较大而且很深,需要先手术治疗,然后再做试管婴儿,不然就会降低移植的成功率。一般来说,子宫其实有积液都不能直接进行移植,直接移植一次成功的几率是非常低的,可能连20%都不到。通常都需要进行治疗,等子宫恢复正常不存在积液之后再移植,成功率会更高一些。
子宫憩室有积液不能直接做试管婴儿
当然不同情况和程度的子宫憩室做试管婴儿一次就成功的几率都是不同的,下面就为大家详细介绍一下不同情况下子宫憩室试管一次成功的几率:
1如果子宫憩室比较小并且没有出现其他的不适症状的话,那么是不需要进行特殊的治疗的,直接试管的成功率也能在50%左右;2如果子宫憩室比较大并且有积液存在的话,是需要先治疗排出积液之后在进行试管的,这样才能够避免影响试管的成功率。

发表评论